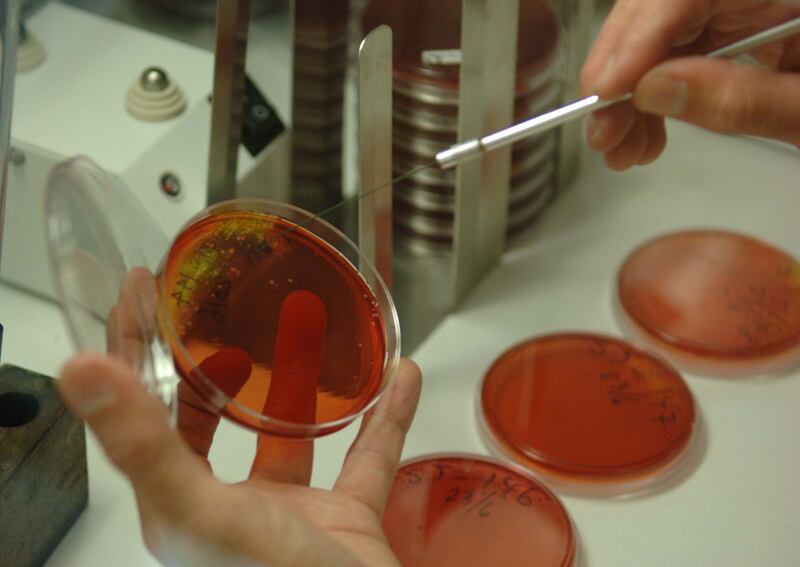

Una vacuna experimental contra la bacteria Clostridium difficile será la meta inicial del nuevo Instituto de Investigación en Ciencias Médicas (Icimed), primer espacio privado para estudios biomédicos en seres humanos que abre puertas en el país.
Este microorganismo provoca diarreas y cuadros intestinales agudos, así como deshidratación. Por sí mismo no es potencialmente grave, pero puede serlo cuando el paciente está débil por otras enfermedades.
“Esta bacteria afecta a muchas personas, especialmente adultos mayores, con enfermedades complejas, que están en hospitales y en tratamiento con antibióticos (...) esto podría ayudarles a muchos costarricenses”, resaltó la directora del Icimed, María del Carmen García.
La entidad, inaugurada ayer, pertenece a la Universidad de Ciencias Médicas (Ucimed).
En la actualidad, el Hospital Max Peralta de Cartago registra un brote de la bacteria. También hay casos en el San Juan de Dios y el Hospital de Puntarenas.
Interdisciplinario. El Icimed contará con médicos, nutricionistas y farmacéuticos, entre otros.
“Toda universidad prestigiosa en el mundo tiene no solo un buen currículo académico, también una fuerte línea de investigación; no podemos quedarnos atrás”, comentó Pablo Guzmán, rector de la Ucimed.
En el Instituto todo proyecto requerirá el visto bueno de un comité ético-científico (CEC), el cual auditará, además, por lo menos una vez al año, cada una de las investigaciones. De hecho, el proyecto de la Clostridium difficile está por entrar en esa fase.
“El paciente debe saber en qué está participando, saberse protegido y con beneficios mucho mayores a los riesgos”, expresó Jorge Quesada, director del CEC.
